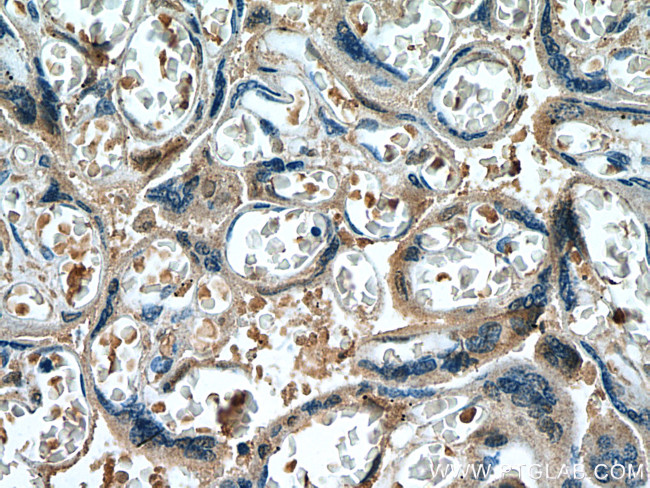
FURIN Antibody in Immunohistochemistry (Paraffin) (IHC (P))

Search
Proteintech
FURIN Monoclonal Antibody (1D1B9)
{{$productOrderCtrl.translations['antibody.pdp.commerceCard.promotion.promotions']}}
{{$productOrderCtrl.translations['antibody.pdp.commerceCard.promotion.viewpromo']}}
{{$productOrderCtrl.translations['antibody.pdp.commerceCard.promotion.promocode']}}: {{promo.promoCode}} {{promo.promoTitle}} {{promo.promoDescription}}. {{$productOrderCtrl.translations['antibody.pdp.commerceCard.promotion.learnmore']}}
产品信息
67481-1-IG
种属反应
宿主/亚型
分类
类型
克隆号
抗原
偶联物
形式
浓度
规格
纯化类型
保存液
内含物
保存条件
运输条件
产品详细信息
Aliquoting is unnecessary for -20°C storage.
靶标信息
Furin is a membrane-associated, calcium-dependent, serine protease that belongs to the subtilisin-like prohormone convertase (PC) family. Members of this family of cellular enzymes cleave most prohormones and neuropeptide precursors. Numerous other cellular proteins, some viral proteins, and bacterial toxins that are transported by the constitutive secretory pathway are also targeted for maturation by PCs. Furin and other PC family members share structural similarities which include a heterogeneous ~10 kDa amino-terminal proregion, a highly conserved ~55 kDa subtilisin-like catalytic domain, and carboxyl-terminal domain that is heterogeneous in length and sequence. These enzymes become catalytically active following proregion cleavage within the appropriate cellular compartment. Furin is the only known PC to possess a transmembrane domain. Cleavage of target proteins occurs at the carboxyl-terminus of the furin consensus sequence, RX(K/R)R. It has been shown that the acidic peptide sequence, C771PSDSEEDEG780, localizes furin to the trans-Golgi-network. Phosphorylation of serine residues within this region modulates intracellular routing of furin protein. An additional signaling domain includes the tetrapeptide sequence, Y759KGL762, which directs internalization from the cell surface.
仅用于科研。不用于诊断过程。未经明确授权不得转售。
篇参考文献 (0)
生物信息学
蛋白别名: dibasic processing enzyme; Dibasic-processing enzyme; FES upstream region; Furin; furin, membrane associated receptor protein; PACE; paired basic amino acid residue cleaving enzyme; Paired basic amino acid residue-cleaving enzyme; Prohormone convertase 3; proprotein convertase subtilisin/kexin 3; proprotein convertase subtilisin/kexin type 3; subtilisin pro-protein processing enzyme; subtilisin-like proprotein convertase 1; unnamed protein product
基因别名: 9130404I01Rik; FUR; FURIN; PACE; PCSK3; SPC1
UniProt ID: (Human) P09958, (Mouse) P23188
Entrez Gene ID: (Human) 5045, (Mouse) 18550